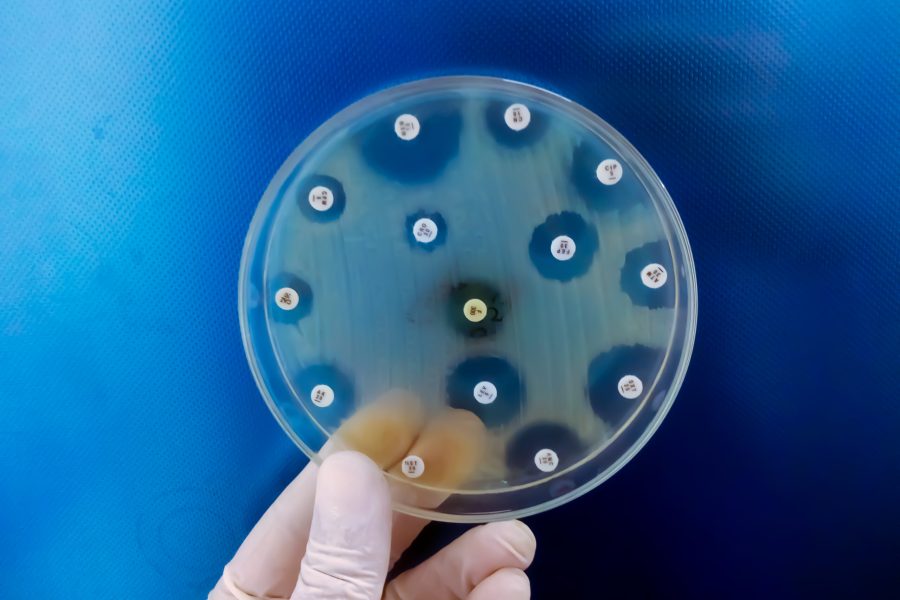
hand-holding-culture-plate-bacterial-growth-showing-antibiotic-sensitivity-their-colony (1)

#OMS
#OMS
Histórico de Notícias Publicadas

O país já havia conquistado a certificação em 2016, mas, em 2018, diante das baixas...
“Educar, defender e agir agora” é tema central da campanha Com o tema central “Educar,...

ALAMEDA SALVADOR, 1057 – COND. SALVADOR SHOPPING BUSINESS - EDF. TORRE AMÉRICA - SALA 307/308 – CAM.DAS ARVORES CEP 41.820-790 - SALVADOR / BA
Histórico de Notícias Publicadas

O país já havia conquistado a certificação em 2016, mas, em 2018, diante das baixas...
“Educar, defender e agir agora” é tema central da campanha Com o tema central “Educar,...